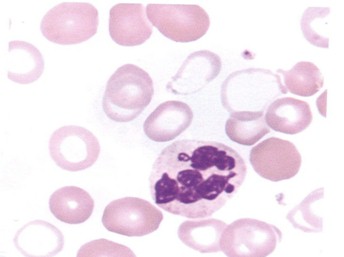

Médula ósea
La médula ósea generalmente tiene una celularidad normal o aumentada y es de utilidad para detectar alteraciones citogenéticas que son determinantes para el diagnóstico y su evolución.
Serie eritroide: hiperplasia, hipoplasia (síndrome mielodisplásico (SMD) hipoplásico), megaloblastos, bi o multinucleados, lobulación, fragmentación y picnosis nuclear; puentes internucleares, cuerpos de Howell-Jolly y sideroblastos en anillo.
Serie mieloide: hiperplasia o hipoplasia granulocítica, promielocitos y mielocitos hiper o hipogranulares, disminución de neutrófilos e incremento de blastos con o sin bastones de Auer, aumento de monocitos y promonocitos.
Serie megacariocítica: micromegacariocitos mono o binucleares, incremento o disminución de megacariocitos, megacariocitos grandes con núcleo no lobulado y megacariocitos multinucleados, emperilopolesis, núcleos no interconectados entre sí, megacariocitos poliploides e hipoploides
Biopsia de médula ósea.
En el estudio histopatológico de la médula ósea, es factible encontrar los ALIPS (precursores inmaduros de localización anómala), como máxima expresión de displasia. Los ALIPS consisten en agrupaciones de mieloblastos y promielocitos localizados en áreas centrales de la médula ósea, en vez de su localización habitual en los espacios trabeculares y perivasculares o de La megacariopoyesis hacia áreas próximas de las trabéculas óseas. La presencia de tres o más de estos focos en una sección medular se considera ALIPS- positiva; siempre que cumpla el requisito de ser mieloperoxidasa positiva, para diferenciarlos de otras agrupaciones celulares (pseudo-ALIPS) que carecen de significado patológico.
Alteraciones morfológicas en médula ósea
Serie roja

Diseritropoyesis. Precursor eritrocítico con pérdida parcial del núcleo
Serie blanca
Dismielopoyesis. Neutrófilo hipersegmentado e hipogranular
Serie plaquetaria

Dismegacariopoyesis. Megacariocito con núcleos anormales
Estudios citogenéticos
Actualmente las anormalidades citogenéticas se detectan con la hibridación in situ por fluorescencia, usando iniciadores de ADN específico; puede ser realizada en la interfase nuclear como metafase y no depende de la división celular. Igualmente, la técnica de PCR es una herramienta importante para identificar anormalidades citogenéticas clónales, es extremadamente sensible y puede proveer un diagnóstico rápido; su desventaja es que no puede ser usada para detectar pérdida o ganancia de cromosomas. Tres (3) alteraciones citogenéticas son descritas en los síndromes mielodisplásicos (SMD): cariotipo normal, alteraciones cromosómicas balanceadas que llevan a la generación de oncogenes de fusión y cariotipo complejo. La delección aislada del brazo largo del cromosoma 5 representa una entidad clínica única que predomina en mujeres en un 75% y se caracteriza por una evolución larga que progresa a leucemia en un 35% de los pacientes. La neutropenia es leve y el contaje plaquetario a veces es alto.
TRATAMIENTO
Hay que tener presente dos premisas importantes para el tratamiento de los pacientes con síndrome mielodisplásico (SMD): primero, la reserva de células progenitoras hematopoyéticas normales declina con la edad, por lo tanto, los pacientes con enfermedad avanzada e inicio tardío tiene muy poca reserva medular y, segundo, que la evolución clínica es diferente en cada paciente, por lo cual, es importante evaluar los factores pronósticos individualmente. Los objetivos del tratamiento del síndrome mielodisplásico (SMD) son:
1. Mantener la hematopoyesis residual para orientar una adecuada terapia
2. Estimular los progenitores hematopoyéticos residuales normales y/o mejorar la eficacia de la hematopoyesis mielodisplásica
3. Erradicar el clon mielodisplásico y restaurar la hematopoyesis normal.
Eritropoyetina humana recombinante (EHR).
La anemia es el principal problema clínico de los pacientes con síndrome mielodisplásico (SMD) por lo que son necesarias transfusiones sanguíneas y su consecuencia, la hemocromatosis secundaria; lamentablemente la gran mayoría de los pacientes son dependientes de las transfusiones y sólo un 15 a 20% de ellos responden al tratamiento con Eritropoyetina humana recombinante (EHR). Los factores que predicen una buena respuesta a la eritropoyetina son los niveles séricos bajos de eritropoyetina (< 100 mu/mL), sexo femenino y cariotipo normal. La persistencia de anemia en el síndrome mielodisplásico (SMD) hace esperar que los pacientes tengan altos niveles séricos de eritropoyetina y resistencia a la misma. La dosis requerida es de aproximadamente 450 IU/kg semanalmente.